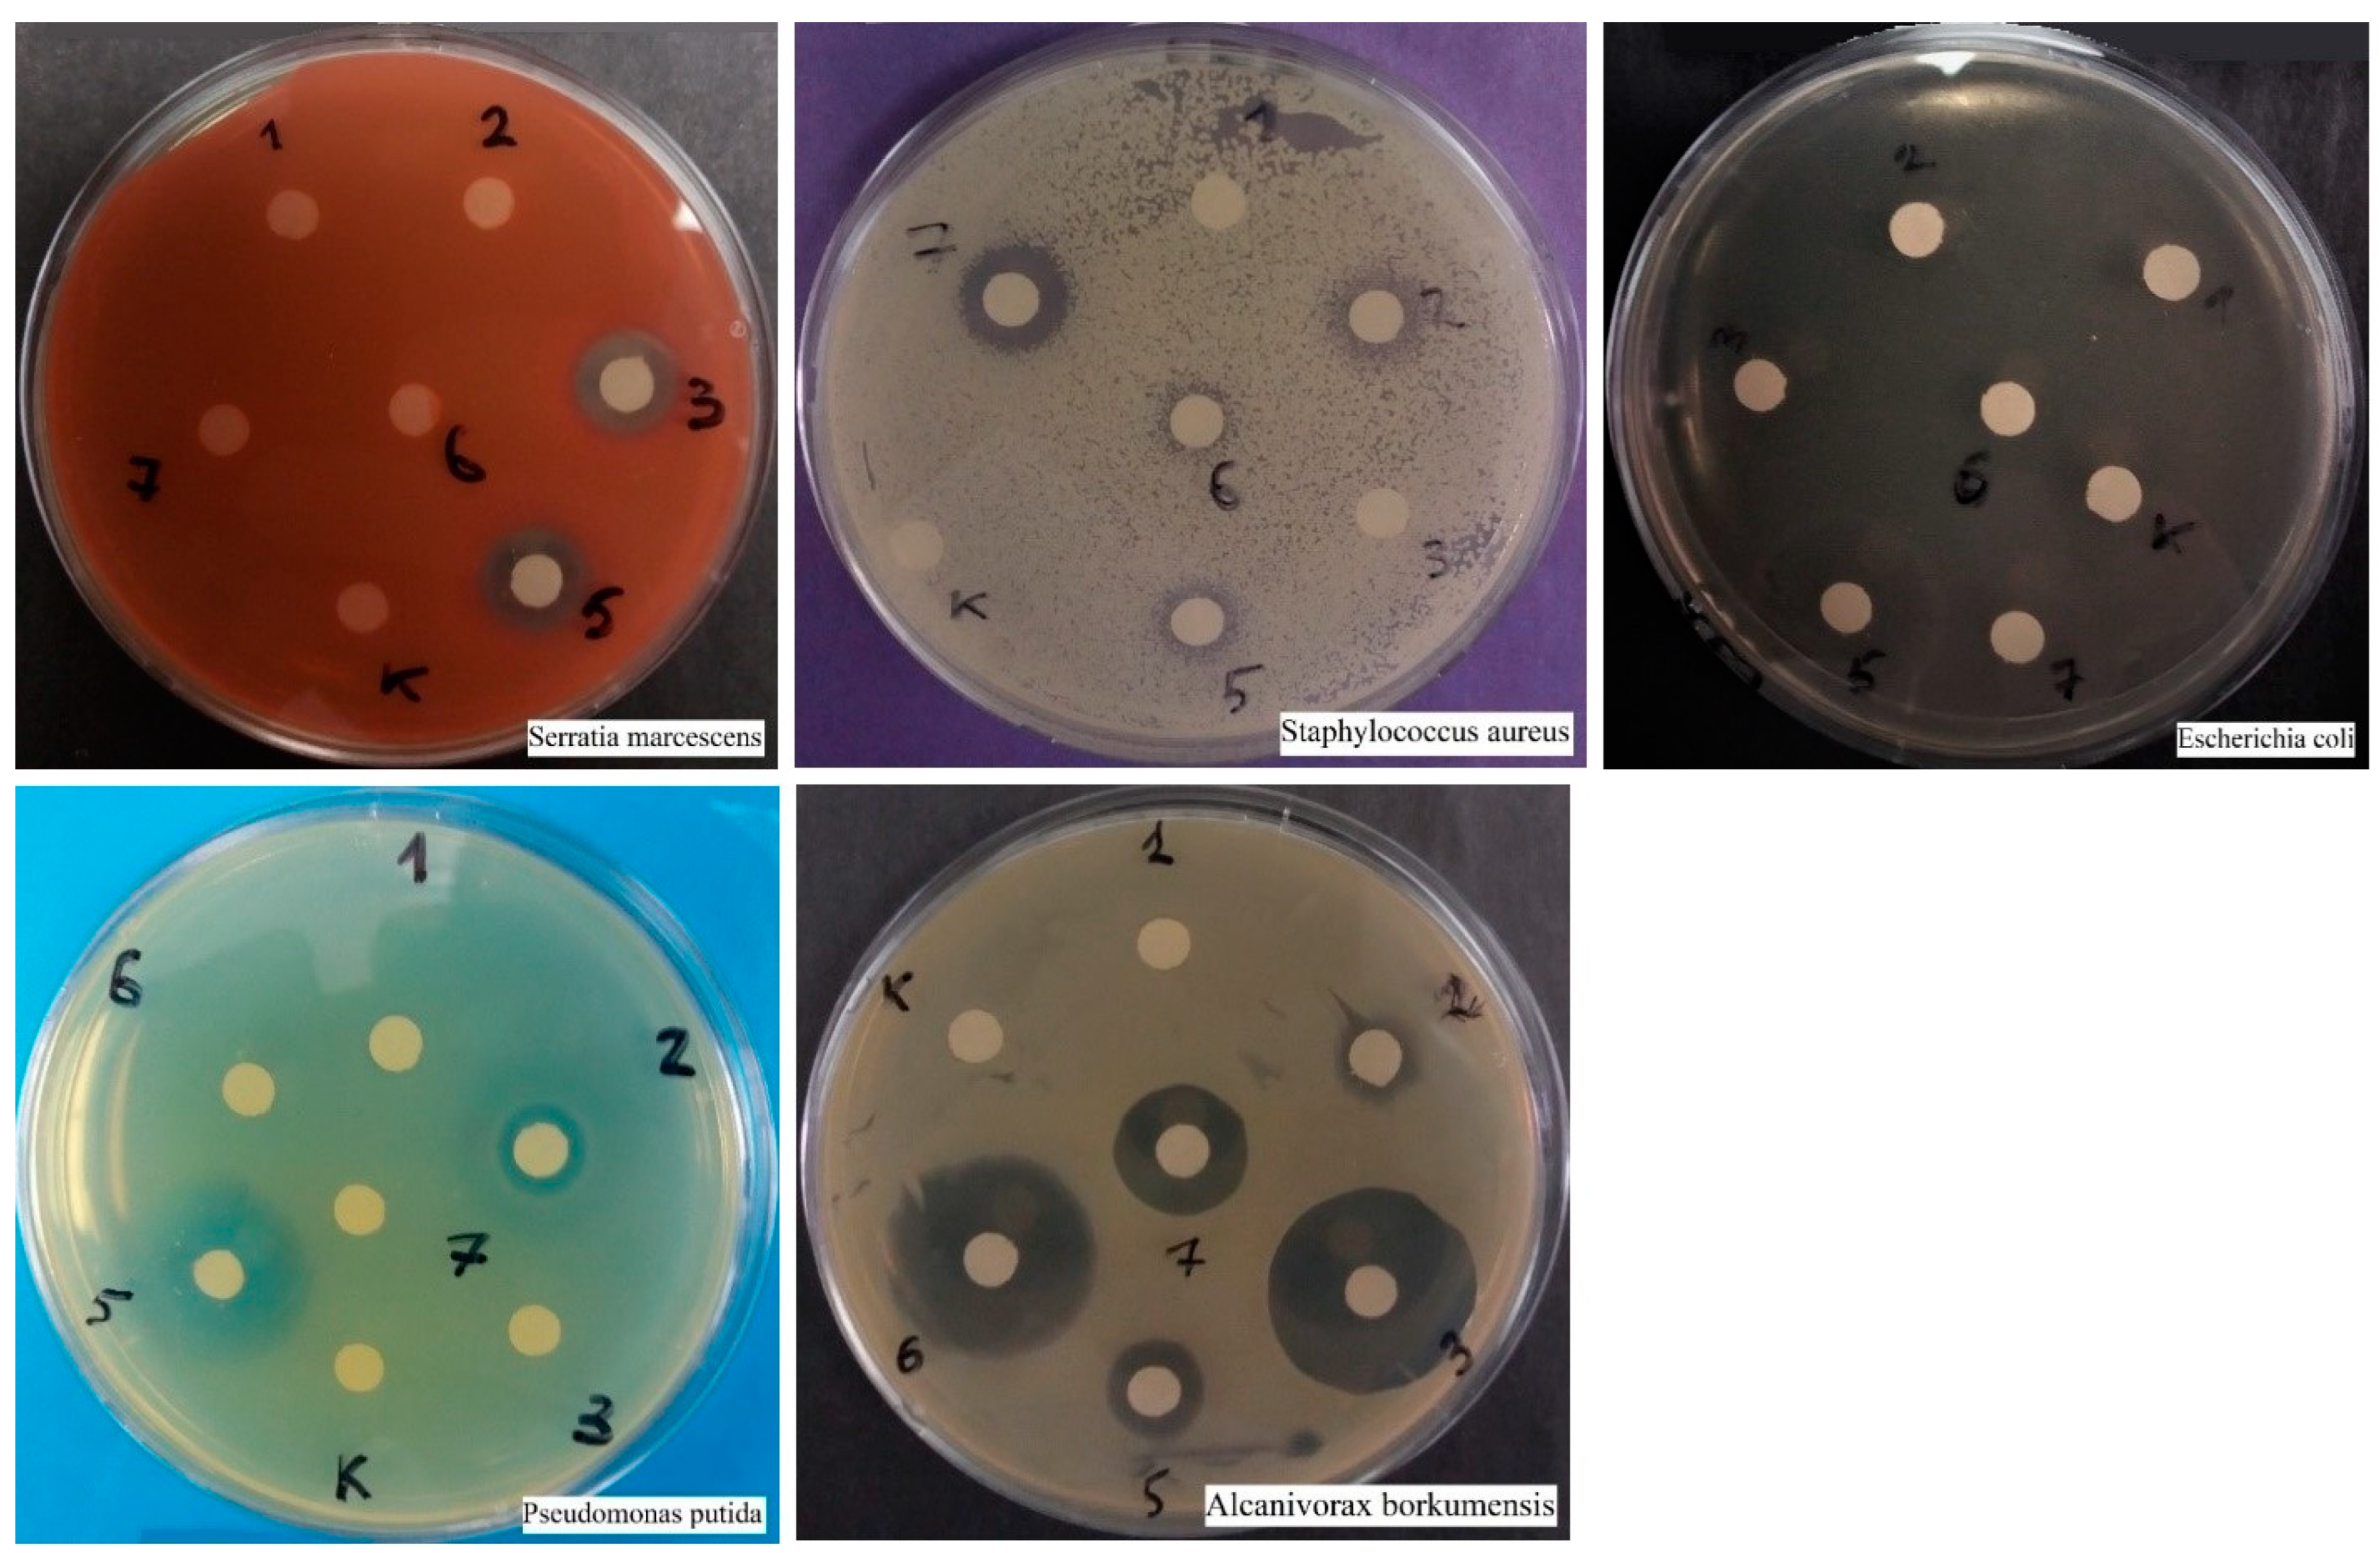
Ijms 25 12494 g004
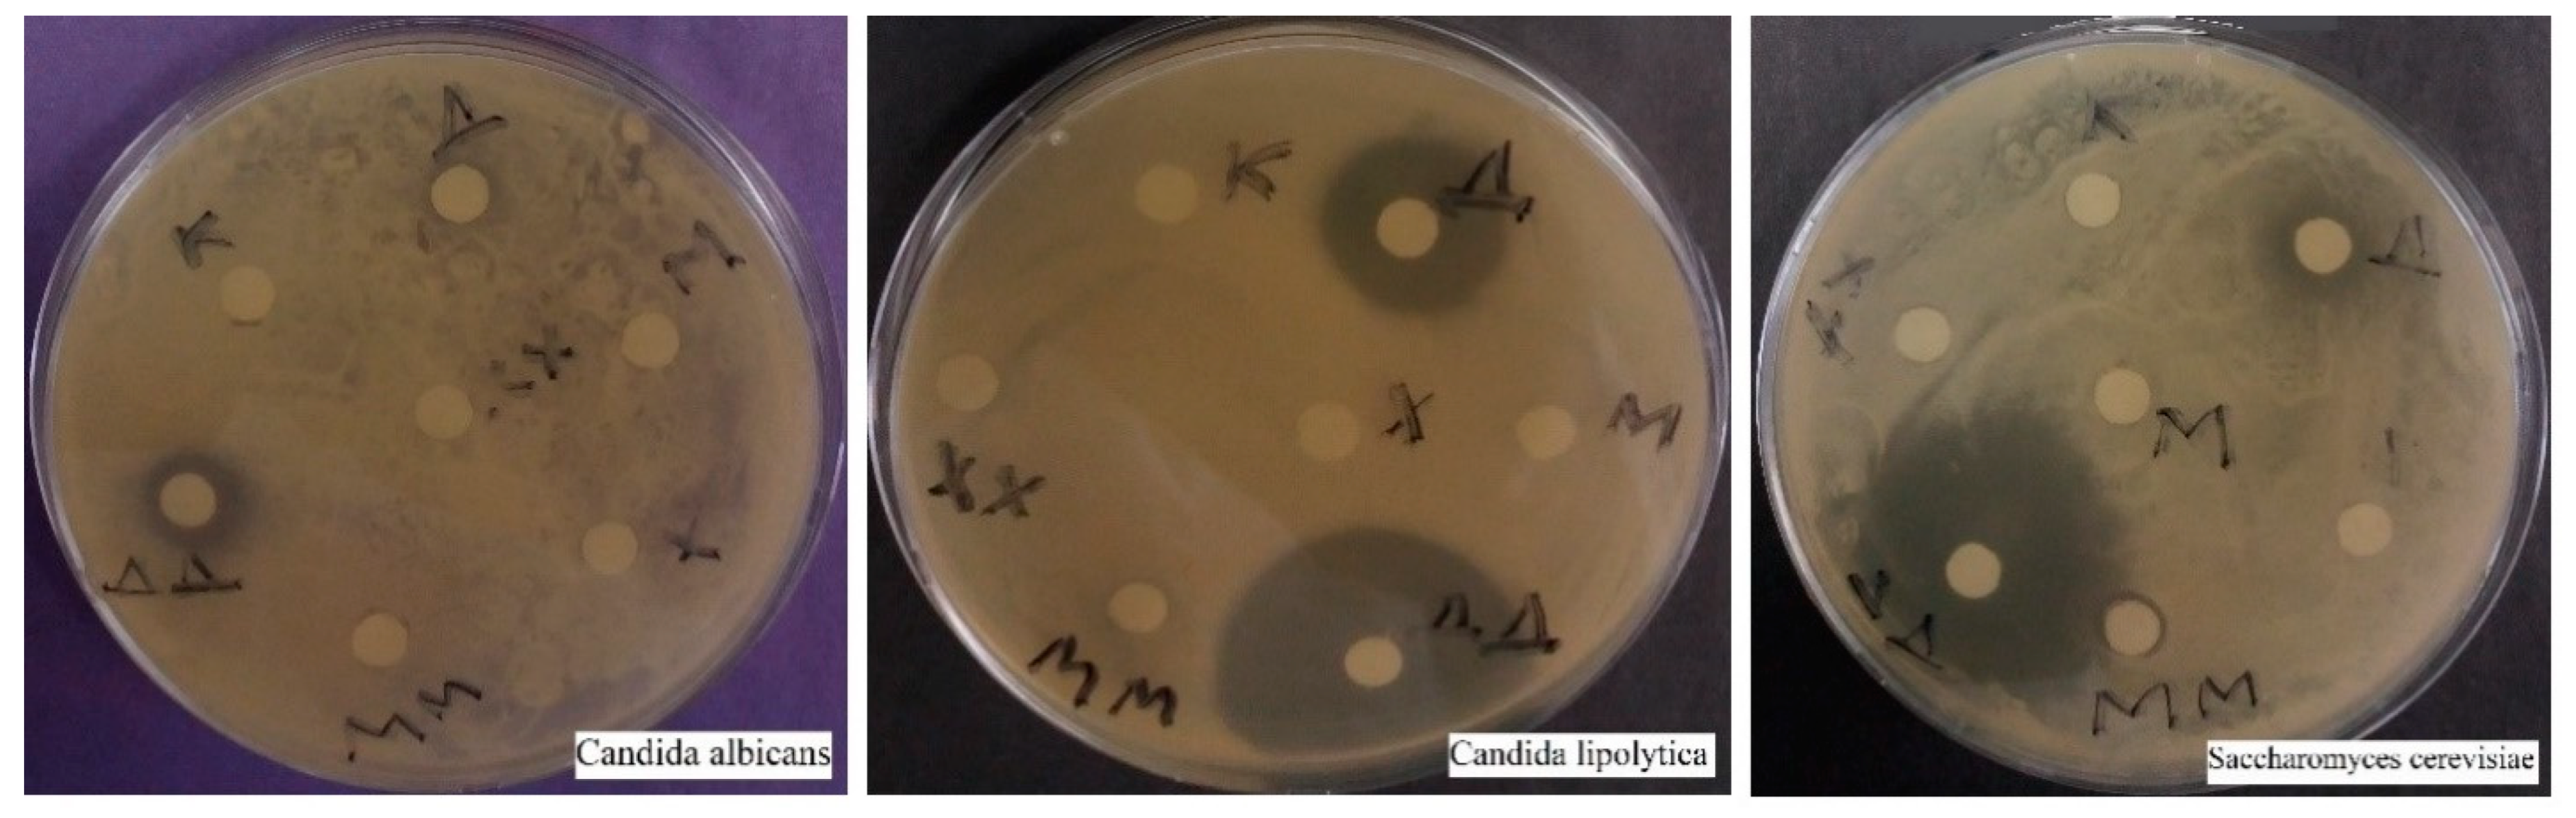
Ijms 25 12494 g005

Antimicrobial and Antifungal Action of Biogenic Silver Nanoparticles in Combination with Antibiotics and Fungicides Against Opportunistic Bacteria and Yeast
Abstract
1. Introduction
2. Results
2.1. Antimicrobial and Antifungal Activity of Silver Nanoparticles
2.1.1. Disco Diffusion Analysis of Various Concentrations of Silver Nanoparticles
2.1.2. Anti-Biofilm Bactericidal Effect of Silver Nanoparticles, Shown Using a Replicator Stamp
2.1.3. Growth Curves of Planktonic Crops in the Presence of Silver Nanoparticles
Staphylococcus aureus
Escherichia coli
Serratia marcescens
Candida albicans
2.2. Research on the Effectiveness of Antibiotics and Fungicides
2.2.1. Comparative Disco-Diffusion Analysis of Six Antibiotics
2.2.2. Comparative Disco-Diffusion Analysis of Three Fungicides
2.3. Growth Curves of Planktonic Crops in the Presence of Silver Nanoparticles, Together with an Antibiotic or Fungicide
2.3.1. Pseudomonas putida
2.3.2. Alcanivorax borkumensis
2.3.3. Escherichia coli
2.3.4. Serratia marcescens
2.3.5. Staphylococcus aureus
2.3.6. Candida albicans
2.3.7. Candida serelytica
2.3.8. Saccharomyces cerevisiae
2.4. Atomic Force Microscopy Study Results
2.4.1. Effect of Ciprofloxacin and Silver Nanoparticles on S. marcescens Biofilms
2.4.2. Changes in the Morphology of E. coli and S. marcescens Cells When Exposed to AgNPs
3. Discussion
4. Materials and Methods
4.1. Biogenic Synthesis of Silver Nanoparticles Using Sphagnum Moss Extract
4.2. Characteristics of the Obtained Nanoparticles
4.3. The Research Objects
4.4. Methods of Research on Antibacterial and Antifungal Effects
5. Conclusions
- (1)
- The synthesis of biogenic silver nanoparticles using an aqueous extract of sphagnum moss (Sphagum fallax) was applied for the first time. Stable biogenic silver nanoparticles of rounded and irregular shape, ranging in size from 10 to 50 nm, with pronounced antimicrobial and antifungal effects, have been obtained.
- (2)
- The effectiveness of different concentrations of nanoparticles against opportunistic bacteria and yeast was analyzed (in two-day experiments). For S. aureus and E. coli, the effect appears at 50 μg/mL; growth suppression occurred at 100 μg/mL. For the bacterium S. marcescens, the effect appeared at 25 μg/mL, but growth suppression occurred in the range from 200 to 500 μg/mL. The antifungal effect of nanoparticles on C. albicans appeared at 100 μg/mL; complete suppression occurred at 300 μg/mL.
- (3)
- The possibilities of reducing the dosages of antibiotics and silver nanoparticles when used together against opportunistic bacteria were analyzed. When analyzing small concentrations, the greatest synergistic effect was observed at S. aureus and P. putida; an insignificant effect was found at S. marcescens and A. borkumensis, and there was no such effect at E. coli. The most resistant species to silver nanoparticles were S. aureus and S. marcescens, and the least—E. coli and A. borkumensis. E. coli turned out to be the species with the greatest vulnerability, both to nanoparticles and to an antibiotic.
- (4)
- In three species of yeast (C. albicans, C. lipolytica, and S. cerevisiae), a synergistic effect was observed with the combined use of silver nanoparticles and a fungicide; the most effect was at the brewer’s yeast. The most resistant species to silver nanoparticles turned out to be C. albicans, and the least resistant was C. lipolytica.
- (5)
- Silver nanoparticles were much more effective in the thickness of the suspension when stirred than at rest, concentrated in the bottom layer.
Author Contributions
Funding
Institutional Review Board Statement
Informed Consent Statement
Data Availability Statement
Acknowledgments
Conflicts of Interest
References
- de Oliveira Santos, J.V.; da Costa Júnior, S.D.; de Fátima Ramos dos Santos Medeiros, S.M.; Cavalcanti, I.D.L.; de Souza, J.B.; Coriolano, D.L.; da Silva, W.R.C.; Menezes, M.H.; Alves, E.; Cavalcanti, I.M.F. Panorama of bacterial infections caused by epidemic resistant strains. Curr. Microbiol. 2022, 79, 175. [Google Scholar] [CrossRef] [PubMed]
- Bai, H.J.; Geng, Q.F.; Jin, F.; Yang, Y.L. Epidemiologic analysis of antimicrobial resistance in hospital departments in China from 2022 to 2023. J. Health Popul. Nutr. 2024, 43, 39. [Google Scholar] [CrossRef] [PubMed]
- Gastmeier, P.; Kola, A.; Schwab, F.; Behnke, M.; Geffers, C. Etiology of nosocomial infections in intensive care patients in German hospitals: An analysis of trends between 2008 and 2022. Int. J. Med. Microbiol. 2024, 314, 151594. [Google Scholar] [CrossRef] [PubMed]
- Fernández-Martínez, N.F.; Rivera-Izquierdo, M.; Ortiz-González-Serna, R.; Martínez-Ruiz, V.; Lardelli-Claret, P.; Aginagalde-Llorente, A.H.; del Carmen Valero-Ubierna, M.; Vergara-Díaz, M.A.; Lorusso, N. Healthcare-associated infections by multidrug-resistant bacteria in Andalusia, Spain, 2014 to 2021. Eurosurveillance 2023, 28, 2200805. [Google Scholar] [CrossRef]
- Nițescu, B.; Pițigoi, D.; Tălăpan, D.; Nițescu, M.; Aramă, S.Ș.; Pavel, B.; Streinu-Cercel, A.; Rafila, A.; Aramă, V. Etiology and Multi-Drug Resistant Profile of Bacterial Infections in Severe Burn Patients, Romania 2018–2022. Medicina 2023, 59, 1143. [Google Scholar] [CrossRef]
- Cerini, P.; Meduri, F.R.; Tomassetti, F.; Polidori, I.; Brugneti, M.; Nicolai, E.; Bernardini, S.; Pieri, M.; Broccolo, F. Trends in antibiotic resistance of nosocomial and community-acquired infections in Italy. Antibiotics 2023, 12, 651. [Google Scholar] [CrossRef]
- Padilla-Garfias, F.; Ríos-Cifuentes, L.; Sánchez, N.S.; Calahorra, M.; Peña, A. Study of the mechanism of ε-poly-L-lysine as an antifungal on Candida albicans and Saccharomyces cerevisiae. Biochim. Biophys. Acta (BBA)-Gen. Subj. 2022, 1866, 130197. [Google Scholar] [CrossRef]
- Franconi, I.; Rizzato, C.; Poma, N.; Tavanti, A.; Lupetti, A. Candida parapsilosis sensu stricto antifungal resistance mechanisms and associated epidemiology. J. Fungi 2023, 9, 798. [Google Scholar] [CrossRef]
- Sharma, C.; Kadosh, D. Perspective on the origin, resistance, and spread of the emerging human fungal pathogen Candida auris. PLoS Pathog. 2023, 19, e1011190. [Google Scholar] [CrossRef]
- Pérez-Torrado, R.; Querol, A. Opportunistic strains of Saccharomyces cerevisiae: A potential risk sold in food products. Front. Microbiol. 2016, 6, 172618. [Google Scholar] [CrossRef]
- Güler, A.; Şarkaya, K.; Kavakcıoğlu Yardımcı, B. Evaluation of the antiproliferative and oxidative effects of polymeric cryogels on the model eukaryotic yeast Saccharomyces cerevisiae. Biologia 2024, 79, 2933–2943. [Google Scholar] [CrossRef]
- Palani, G.; Trilaksana, H.; Sujatha, R.M.; Kannan, K.; Rajendran, S.; Korniejenko, K.; Nykiel, M.; Uthayakumar, M. Silver nanoparticles for waste water management. Molecules 2023, 28, 3520. [Google Scholar] [CrossRef] [PubMed]
- Rasheed, A.; Hussain, S.; Mushtaq, W.; Zubair, M.; Siddique, K.; Attia, K.; Khan, N.; Faiz, S.; Azeem, F.; Chen, Y. Application of silver nanoparticles synthesized through varying biogenic and chemical methods for wastewater treatment and health aspects. Environ. Sci. Pollut. Res. 2023, 1–18. [Google Scholar] [CrossRef] [PubMed]
- Awad, M.A.; Virk, P.; Hendi, A.A.; Ortashi, K.M.; AlMasoud, N.; Alomar, T.S. Role of Biosynthesized Silver Nanoparticles with Trigonella foenum-graecum Seeds in Wastewater Treatment. Processes 2023, 11, 2394. [Google Scholar] [CrossRef]
- Khan, S.; Zahoor, M.; Khan, R.S.; Ikram, M.; Islam, N.U. The impact of silver nanoparticles on the growth of plants: The agriculture applications. Heliyon 2023, 9, e16928. [Google Scholar] [CrossRef]
- Paulami, D.A.M.; Paret, M.L.; Mondal, R.; Mandal, A.K. Advancement of noble metallic nanoparticles in agriculture: A promising future. Pedosphere 2023, 33, 116–128. [Google Scholar]
- Tariq, M.; Mohammad, K.N.; Ahmed, B.; Siddiqui, M.A.; Lee, J. Biological synthesis of silver nanoparticles and prospects in plant disease management. Molecules 2022, 27, 4754. [Google Scholar] [CrossRef]
- Zhang, S.; Jiang, W.; Liu, G.; Liu, S.; Chen, H.; Lyu, G.; Yang, G.; Liu, Y.; Ni, Y. Preparation of ultrafine and highly loaded silver nanoparticle composites and their highly efficient applications as reductive catalysts and antibacterial agents. J. Colloid Interface Sci. 2023, 629, 766–777. [Google Scholar] [CrossRef]
- Abu-Dief, A.M.; Abdel-Rahman, L.H.; Sayed, M.A.E.; Zikry, M.M.; Khalifa, M.E.; El-Metwaly, N.M. Optimization strategy for green synthesis of silver nanoparticles (AgNPs) as catalyst for the reduction of 2,4-dinitrophenol via supported mechanism. Appl. Phys. A 2022, 128, 595. [Google Scholar] [CrossRef]
- Das, T.K.; Ghosh, S.K.; Das, N.C. Green synthesis of a reduced graphene oxide/silver nanoparticles-based catalyst for degradation of a wide range of organic pollutants. Nano-Struct. Nano-Objects 2023, 34, 100960. [Google Scholar] [CrossRef]
- Möhler, J.S.; Sim, W.; Blaskovich, M.A.; Cooper, M.A.; Ziora, Z.M. Silver bullets: A new lustre on an old antimicrobial agent. Biotechnol. Adv. 2018, 36, 1391–1411. [Google Scholar] [CrossRef] [PubMed]
- Princy, S.S.J.; Hentry, C.; Alodaini, H.A.; Hatamleh, A.A.; Arokiyaraj, S.; Bindhu, M.R. Hibiscus cannabinus seeds assisted spherical silver nanoparticles and its antibacterial and photocatalytic applications. Chem. Phys. Impact 2023, 6, 100192. [Google Scholar] [CrossRef]
- Balčiūnaitienė, A.; Liaudanskas, M.; Puzerytė, V.; Viškelis, J.; Janulis, V.; Viškelis, P.; Griškonis, E.; Jankauskaitė, V. Eucalyptus globulus and Salvia officinalis extracts mediated green synthesis of silver nanoparticles and their application as an antioxidant and antimicrobial agent. Plants 2022, 11, 1085. [Google Scholar] [CrossRef] [PubMed]
- Zeng, A.; Yang, R.; Tong, Y.; Zhao, W. Functional bacterial cellulose nanofibrils with silver nanoparticles and its antibacterial application. Int. J. Biol. Macromol. 2023, 235, 123739. [Google Scholar] [CrossRef]
- Chandraker, S.K.; Kumar, R. Biogenic biocompatible silver nanoparticles: A promising antibacterial agent. Biotechnol. Genet. Eng. Rev. 2022, 1–35. [Google Scholar] [CrossRef]
- Abeer Mohammed, A.B.; Abd Elhamid, M.M.; Khalil, M.K.M.; Ali, A.S.; Abbas, R.N. The potential activity of biosynthesized silver nanoparticles of Pseudomonas aeruginosa as an antibacterial agent against multidrug-resistant isolates from intensive care unit and anticancer agent. Environ. Sci. Eur. 2022, 34, 109. [Google Scholar] [CrossRef]
- Mumtaz, S.; Ali, S.; Mumtaz, S.; Mughal, T.A.; Tahir, H.M.; Shakir, H.A. Chitosan conjugated silver nanoparticles: The versatile antibacterial agents. Polym. Bull. 2023, 80, 4719–4736. [Google Scholar] [CrossRef]
- Shinde, B.H.; Inamdar, S.N.; Nalawade, S.A.; Chaudhari, S.B. A systematic review on antifungal and insecticidal applications of biosynthesized metal nanoparticles. Mater. Today Proc. 2023, 73, 412–417. [Google Scholar] [CrossRef]
- Ribeiro, L.G.; Roque, G.S.C.; Conrado, R.; De Souza, A.O. Antifungal activity of mycogenic silver nanoparticles on clinical yeasts and phytopathogens. Antibiotics 2023, 12, 91. [Google Scholar] [CrossRef]
- Sweedan, E.G.; Majeed, S.M.A. Effects of Silver Nanoparticles Synthesized from Phenolic Extract of Agaricus bisporus Against Pathogenic Bacteria and Yeasts. Nano Biomed. Eng. 2023, 15, 86–95. [Google Scholar] [CrossRef]
- Elnagar, R.M.; Elshaer, M.; El-Raouf, A.; Mona, A. Silver nanoparticles display inhibitory effect against drug-resistant pathogenic Candida isolates from different clinical specimens. Egypt. J. Bot. 2023, 63, 305–314. [Google Scholar] [CrossRef]
- Al-Askar, A.A.; Aseel, D.G.; El-Gendi, H.; Sobhy, S.; Samy, M.A.; Hamdy, E.; El-Messeiry, S.; Behiry, S.I.; Elbeaino, T.; Abdelkhalek, A. Antiviral Activity of Biosynthesized Silver Nanoparticles from Pomegranate (Punica granatum L. Peel Extract against Tobacco Mosaic Virus. Plants 2023, 12, 2103. [Google Scholar] [CrossRef] [PubMed]
- Luceri, A.; Francese, R.; Lembo, D.; Ferraris, M.; Balagna, C. Silver nanoparticles: Review of antiviral properties, mechanism of action and applications. Microorganisms 2023, 11, 629. [Google Scholar] [CrossRef] [PubMed]
- Algazlan, A.S.; Almuraikhi, N.; Muthurangan, M.; Balto, H.; Alsalleeh, F. Silver nanoparticles alone or in combination with calcium hydroxide modulate the viability, attachment, migration, and osteogenic differentiation of human mesenchymal stem cells. Int. J. Mol. Sci. 2022, 24, 702. [Google Scholar] [CrossRef]
- Mendes-Gouvêa, C.C.; Danelon, M.; Vieira, A.P.M.; do Amaral, J.G.; de Souza Neto, F.N.; Gorup, L.F.; Camargo, E.R.; Botazzo Delbem, A.C.; Barbosa, D.B.; Barbosa, D.B. Silver nanoparticles associated with a polyphosphate and fluoride enhance the prevention of enamel demineralization and impact on dual-biofilm adhesion. J. Dent. 2022, 125, 104245. [Google Scholar] [CrossRef]
- Mallineni, S.K.; Sakhamuri, S.; Kotha, S.L.; AlAsmari, A.R.G.M.; AlJefri, G.H.; Almotawah, F.N.; Mallineni, S.; Sajja, R. Silver nanoparticles in dental applications: A descriptive review. Bioengineering 2023, 10, 327. [Google Scholar] [CrossRef]
- Sarviya, N.; Mahanta, U.; Dart, A.; Giri, J.; Deshpande, A.S.; Khandelwal, M.; Bhave, M.; Kingshott, P. Biocompatible and antimicrobial multilayer fibrous polymeric wound dressing with optimally embedded silver nanoparticles. Appl. Surf. Sci. 2023, 612, 155799. [Google Scholar] [CrossRef]
- Samatya Yilmaz, S.; Aytac, A. Fabrication and characterization as antibacterial effective wound dressing of hollow polylactic acid/polyurethane/silver nanoparticle nanofiber. J. Polym. Res. 2022, 29, 473. [Google Scholar] [CrossRef]
- Rybka, M.; Mazurek, Ł.; Konop, M. Beneficial effect of wound dressings containing silver and silver nanoparticles in wound healing—From experimental studies to clinical practice. Life 2022, 13, 69. [Google Scholar] [CrossRef]
- Rugaie, O.A.; Abdellatif, A.A.; El-Mokhtar, M.A.; Sabet, M.A.; Abdelfattah, A.; Alsharidah, M.; Aldubaib, M.; Barakat, H.; Abudoleh, S.M.; Al-Refaey, K.A.; et al. Retardation of bacterial biofilm formation by coating urinary catheters with metal nanoparticle-stabilized polymers. Microorganisms 2022, 10, 1297. [Google Scholar] [CrossRef]
- Cabrera-Rodríguez, O.; Trejo-Valdez, M.D.; Torres-SanMiguel, C.R.; Pérez-Hernández, N.; Bañuelos-Hernández, Á.; Manríquez-Ramírez, M.E.; Hernández-Benítez, J.A.; Rodríguez-Tovar, A.V. Evaluation of the performance of TiO2 thin films doped with silver nanoparticles as a protective coating for metal prostheses. Surf. Coat. Technol. 2023, 458, 129349. [Google Scholar] [CrossRef]
- Peralta, L.C.F.; Almeida, N.L.M.; Pontes, F.M.L.; Rinaldo, D.; Carneiro, C.A.; Neppelenbroek, K.H.; Soares Lara, V.; Porto, V.C. Silver nanoparticles in denture adhesive: An antimicrobial approach against Candida albicans. J. Dent. 2023, 131, 104445. [Google Scholar] [CrossRef]
- Hublikar, L.V.; Ganachari, S.V.; Patil, V.B.; Nandi, S.; Honnad, A. Anticancer potential of biologically synthesized silver nanoparticles using Lantana camara leaf extract. Prog. Biomater. 2023, 12, 155–169. [Google Scholar] [CrossRef] [PubMed]
- Tunç, T. Synthesis and characterization of silver nanoparticles loaded with carboplatin as a potential antimicrobial and cancer therapy. Cancer Nanotechnol. 2024, 15, 2. [Google Scholar] [CrossRef]
- Takáč, P.; Michalková, R.; Čižmáriková, M.; Bedlovičová, Z.; Balážová, Ľ.; Takáčová, G. The role of silver nanoparticles in the diagnosis and treatment of cancer: Are there any perspectives for the future? Life 2023, 13, 466. [Google Scholar] [CrossRef] [PubMed]
- Nguyen, N.P.U.; Dang, N.T.; Doan, L.; Nguyen, T.T.H. Synthesis of silver nanoparticles: From conventional to ‘modern’methods—A review. Processes 2023, 11, 2617. [Google Scholar] [CrossRef]
- Ajaykumar, A.P.; Mathew, A.; Chandni, A.P.; Varma, S.R.; Jayaraj, K.N.; Sabira, O.; Rasheed, V.A.; Binitha, V.S.; Swaminathan, T.R.; Basheer, V.S.; et al. Green synthesis of silver nanoparticles using the leaf extract of the medicinal plant, Uvaria narum and its antibacterial, antiangiogenic, anticancer and catalytic properties. Antibiotics 2023, 12, 564. [Google Scholar] [CrossRef]
- Baran, M.F.; Keskin, C.; Baran, A.; Hatipoğlu, A.; Yildiztekin, M.; Küçükaydin, S.; Kurt, K.; Hoşgören, H.; Sarker Md., M.R.; Sufianov, A.; et al. Green synthesis of silver nanoparticles from Allium cepa L. Peel extract, their antioxidant, antipathogenic, and anticholinesterase activity. Molecules 2023, 28, 2310. [Google Scholar] [CrossRef]
- Singh, C.; Anand, S.K.; Upadhyay, R.; Pandey, N.; Kumar, P.; Singh, D.; Tiwari, P.; Saini, R.; Tiwari, K.N.; Mishra, S.K.; et al. Green synthesis of silver nanoparticles by root extract of Premna integrifolia L. and evaluation of its cytotoxic and antibacterial activity. Mater. Chem. Phys. 2023, 297, 127413. [Google Scholar] [CrossRef]
- Arif, M.; Ullah, R.; Ahmad, M.; Ali, A.; Ullah, Z.; Ali, M.; Al-Joufi, F.A.; Zahoor, M.; Sher, H. Green synthesis of silver nanoparticles using Euphorbia wallichii leaf extract: Its antibacterial action against citrus canker causal agent and antioxidant potential. Molecules 2022, 27, 3525. [Google Scholar] [CrossRef]
- Labulo, A.H.; David, O.A.; Terna, A.D. Green synthesis and characterization of silver nanoparticles using Morinda lucida leaf extract and evaluation of its antioxidant and antimicrobial activity. Chem. Pap. 2022, 76, 7313–7325. [Google Scholar] [CrossRef] [PubMed]
- Bazylyak, L.I.; Kytsya, A.R.; Lyutyy, P.Y.; Korets’ka, N.I.; Pilyuk, Y.V.; Kuntyi, O.I. Silver nanoparticles produced via a green synthesis using the rhamnolipid as a reducing agent and stabilizer. Appl. Nanosci. 2023, 13, 5251–5263. [Google Scholar] [CrossRef]
- Motti, R.; Palma, A.D.; de Falco, B. Bryophytes used in folk medicine: An ethnobotanical overview. Horticulturae 2023, 9, 137. [Google Scholar] [CrossRef]
- Bandyopadhyay, A.; Dey, A. The ethno-medicinal and pharmaceutical attributes of Bryophytes: A review. Phytomedicine Plus 2022, 2, 100255. [Google Scholar] [CrossRef]
- Painter, T.J. Concerning the wound-healing properties of Sphagnum holocellulose: The Maillard reaction in pharmacology. J. Ethnopharmacol. 2003, 88, 145–148. [Google Scholar] [CrossRef]
- Valeeva, L.R.; Dague, A.L.; Hall, M.H.; Tikhonova, A.E.; Sharipova, M.R.; Valentovic, M.A.; Bogomolnaia, L.M.; Shakirov, E.V. Antimicrobial activities of secondary metabolites from model mosses. Antibiotics 2022, 11, 1004. [Google Scholar] [CrossRef]
- Benek, A.; Canli, K.; Altuner, E.M. Traditional medicinal uses of mosses. Anatol. Bryol. 2022, 8, 57–65. [Google Scholar] [CrossRef]
- Girma, A. Alternative mechanisms of action of metallic nanoparticles to mitigate the global spread of antibiotic-resistant bacteria. Cell Surf. 2023, 10, 100112. [Google Scholar] [CrossRef]
- Singh, M.; Thakur, V.; Kumar, V.; Raj, M.; Gupta, S.; Devi, N.; Upadhya, S.K.; Macho, M.; Banerjee, A.; Ewe, D.; et al. Silver nanoparticles and its mechanistic insight for chronic wound healing: Review on recent progress. Molecules 2022, 27, 5587. [Google Scholar] [CrossRef]
- Skóra, B.; Piechowiak, T.; Szychowski, K.A. Dual mechanism of silver nanoparticle-mediated upregulation of adipogenesis in mouse fibroblasts (3T3-L1) in vitro. Toxicol. Appl. Pharmacol. 2023, 479, 116726. [Google Scholar] [CrossRef]
- Borase, H.P.; Patil, C.D.; Sauter, I.P.; Rott, M.B.; Patil, S.V. Amoebicidal activity of phytosynthesized silver nanoparticles and their in vitro cytotoxicity to human cells. FEMS Microbiol. Lett. 2013, 345, 127–131. [Google Scholar] [CrossRef] [PubMed]
- Nagesh, M.R.; Vijayakumar, N.; Anandan, R.; Renuka, M.; Amalan, V.; Kavitha, R.; Arulmani, S.R.B.; Ahmed, M.Z.; Alqahtani, A.S.; Nasr, F.A.; et al. Cytotoxic and genotoxic properties of silver nanoparticles synthesized by ethanolic extract of Salacia chinensis. Int. J. Biol. Macromol. 2023, 233, 123506. [Google Scholar] [CrossRef] [PubMed]
- Nie, P.; Zhao, Y.; Xu, H. Synthesis, applications, toxicity and toxicity mechanisms of silver nanoparticles: A review. Ecotoxicol. Environ. Saf. 2023, 253, 114636. [Google Scholar] [CrossRef] [PubMed]
- Hachicho, N.; Hoffmann, P.; Ahlert, K.; Heipieper, H.J. Effect of silver nanoparticles and silver ions on growth and adaptive response mechanisms of Pseudomonas putida mt-2. FEMS Microbiol. Lett. 2014, 355, 71–77. [Google Scholar] [CrossRef]
- More, P.R.; Pandit, S.; Filippis, A.D.; Franci, G.; Mijakovic, I.; Galdiero, M. Silver nanoparticles: Bactericidal and mechanistic approach against drug resistant pathogens. Microorganisms 2023, 11, 369. [Google Scholar] [CrossRef]
- Mikhailova, E.O. Silver nanoparticles: Mechanism of action and probable bio-application. J. Funct. Biomater. 2020, 11, 84. [Google Scholar] [CrossRef]
- Kumar, S.; Paliya, B.S.; Singh, B.N. Superior inhibition of virulence and biofilm formation of Pseudomonas aeruginosa PAO1 by phyto-synthesized silver nanoparticles through anti-quorum sensing activity. Microb. Pathog. 2022, 170, 105678. [Google Scholar] [CrossRef]
- Barabadi, H.; Hosseini, O.; Jounaki, K.; Sadeghian-Abadi, S.; Ashouri, F.; Alrikabi, A.M.A.; Vahidi, H.; Amidi, S.; Mojab, F.; Mohammadi, N.; et al. Bioinspired green-synthesized silver nanoparticles: In vitro physicochemical, antibacterial, biofilm inhibitory, genotoxicity, antidiabetic, antioxidant, and anticoagulant performance. Mater. Adv. 2023, 4, 3037–3054. [Google Scholar] [CrossRef]
- AboElmaaty, S.A.; Shati, A.A.; Alfaifi, M.Y.; Elbehairi, S.E.I.; Sheraba, N.S.; Hassan, M.G.; Badawy, M.S.E.M.; Ghareeb, A.; Hamed, A.A.; Gabr, E.Z. Biofilm inhibitory activity of actinomycete-synthesized AgNPs with low cytotoxic effect: Experimental and in silico study. Microorganisms 2022, 11, 102. [Google Scholar] [CrossRef]
- Pietrzak, K.; Glińska, S.; Gapińska, M.; Ruman, T.; Nowak, A.; Aydin, E.; Gutarowska, B. Silver nanoparticles: A mechanism of action on moulds. Metallomics 2016, 8, 1294–1302. [Google Scholar] [CrossRef]
- Carmo, P.H.F.D.; Garcia, M.T.; Figueiredo-Godoi, L.M.A.; Lage, A.C.P.; Silva, N.S.D.; Junqueira, J.C. Metal nanoparticles to combat candida albicans infections: An update. Microorganisms 2023, 11, 138. [Google Scholar] [CrossRef] [PubMed]
- Szerencsés, B.; Igaz, N.; Tóbiás, Á.; Prucsi, Z.; Rónavári, A.; Bélteky, P.; Madarász, D.; Papp, C.; Makra, I.; Vágvölgyi, C.; et al. Size-dependent activity of silver nanoparticles on the morphological switch and biofilm formation of opportunistic pathogenic yeasts. BMC Microbiol. 2020, 20, 176. [Google Scholar] [CrossRef] [PubMed]
- Durán, N.; Marcato, P.D.; Conti, R.D.; Alves, O.L.; Costa, F.; Brocchi, M. Potential use of silver nanoparticles on pathogenic bacteria, their toxicity and possible mechanisms of action. J. Braz. Chem. Soc. 2010, 21, 949–959. [Google Scholar] [CrossRef]
- Spoladori, L.F.D.A.; Andriani, G.M.; Castro, I.M.D.; Suzukawa, H.T.; Gimenes, A.C.R.; Bartolomeu-Gonçalves, G.; Ishida, K.; Nakazato, G.; Pinge-Filho, P.; Machado, R.R.B.; et al. Synergistic Antifungal Interaction between Pseudomonas aeruginosa LV Strain Metabolites and Biogenic Silver Nanoparticles against Candida auris. Antibiotics 2023, 12, 861. [Google Scholar] [CrossRef] [PubMed]
- Cervantes-Chávez, J.A.; García-Bouchot, G.; García-Gutiérrez, N.; Vergara-Castañeda, H.A.; Nava-Mendoza, R.; Luna-Bárcenas, G.; Elizalde-Peña, E.A.; Esquivel-Naranjo, E.U.; Landeros-Jaime, F.; Rojas-Avelizapa, N.G.; et al. Biogenic Silver Nanoparticles and Stressors Generate Synergistic Growth Inhibition in Candida Species through Cell Wall Damage, Osmotic Stress, and Oxidative Stress. Curr. Pharm. Biotechnol. 2023, 24, 1682–1693. [Google Scholar] [CrossRef]
- Vasiliev, G.; Kubo, A.L.; Vija, H.; Kahru, A.; Bondar, D.; Karpichev, Y.; Bondarenko, O. Synergistic antibacterial effect of copper and silver nanoparticles and their mechanism of action. Sci. Rep. 2023, 13, 9202. [Google Scholar] [CrossRef]
- Gulbagca, F.; Ozdemir, S.; Gulcan, M.; Sen, F. Synthesis and characterization of Rosa canina-mediated biogenic silver nanoparticles for anti-oxidant, antibacterial, antifungal, and DNA cleavage activities. Heliyon 2019, 5, e02980. [Google Scholar] [CrossRef]
- Das, J.; Velusamy, P. Biogenic synthesis of antifungal silver nanoparticles using aqueous stem extract of banana. Nano Biomed Eng. 2013, 5, 34–38. [Google Scholar] [CrossRef]
- Vijayan, S.; Divya, K.; Varghese, S.; Jisha, M.S. Antifungal efficacy of chitosan-stabilized biogenic silver nanoparticles against pathogenic Candida spp. isolated from human. BioNanoScience 2020, 10, 974–982. [Google Scholar] [CrossRef]
- Netala, V.R.; Kotakadi, V.S.; Domdi, L.; Gaddam, S.A.; Bobbu, P.; Venkata, S.K.; Ghosh, S.B.; Tartte, V. Biogenic silver nanoparticles: Efficient and effective antifungal agents. Appl. Nanosci. 2016, 6, 475–484. [Google Scholar] [CrossRef]
- Aabed, K.; Mohammed, A.E. Synergistic and antagonistic effects of biogenic silver nanoparticles in combination with antibiotics against some pathogenic microbes. Front. Bioeng. Biotechnol. 2021, 9, 652362. [Google Scholar] [CrossRef] [PubMed]
- Akhatova, F.; Konnova, S.; Kryuchkova, M.; Batasheva, S.; Mazurova, K.; Vikulina, A.; Volodkin, D.; Rozhina, E. Comparative characterization of iron and silver nanoparticles: Extract-stabilized and classical synthesis methods. Int. J. Mol. Sci. 2023, 24, 9274. [Google Scholar] [CrossRef] [PubMed]
- Konnova, S.A.; Danilushkina, A.A.; Fakhrullina, G.I.; Akhatova, F.S.; Badrutdinov, A.R.; Fakhrullin, R.F. Silver nanoparticle-coated “cyborg” microorganisms: Rapid assembly of polymer-stabilised nanoparticles on microbial cells. RSC Adv. 2015, 5, 13530–13537. [Google Scholar] [CrossRef]
- Iskuzhina, L.; Batasheva, S.; Kryuchkova, M.; Rozhin, A.; Zolotykh, M.; Mingaleeva, R.; Akhatova, F.; Stavitskaya, A.; Cherednichenko, K.; Rozhina, E. Advances in the Toxicity Assessment of Silver Nanoparticles Derived from a Sphagnum fallax Extract for Monolayers and Spheroids. Biomolecules 2024, 14, 611. [Google Scholar] [CrossRef]
- Alqahtani, A.; Marrez, D.A.; Aleraky, M.; Fagir, N.A.; Alqahtani, O.; Othman, S.; El Raey, M.A.; Attia, H.G. Characterization and Isolation of the Major Biologically Active Metabolites Isolated from Ficus retusa and Their Synergistic Effect with Tetracycline against Certain Pathogenic-Resistant Bacteria. Pharmaceuticals 2022, 15, 1473. [Google Scholar] [CrossRef]

| Active Substance | E. coli | S. marcescens | S. aureus | C. albicans |
|---|---|---|---|---|
| Control sample (water) | 0 | 0 | 0 | 0 |
| AgNPs (25 μg/mL) | 0 | 0 | 0 | 0 |
| AgNPs (50 μg/mL) | 0.5 | 0 | 0 | 0 |
| AgNPs (75 μg/mL) | 1 | 1 | 1 | 0 |
| AgNPs (100 μg/mL) | 2 | 1 | 2 | 0 |
| AgNPs (200 μg/mL) | 3 | 2 | 3 | 1 |
| AgNPs (500 μg/mL) | 3 | 3 | 3.5 | 5 |
| AgNPs (1000 μg/mL) | 3 | 3 | 3.5 | 6 |
| Sphagnum extract | 0 | 0 | 0 | 0 |
Disclaimer/Publisher’s Note: The statements, opinions and data contained in all publications are solely those of the individual author(s) and contributor(s) and not of MDPI and/or the editor(s). MDPI and/or the editor(s) disclaim responsibility for any injury to people or property resulting from any ideas, methods, instructions or products referred to in the content. |
© 2024 by the authors. Licensee MDPI, Basel, Switzerland. This article is an open access article distributed under the terms and conditions of the Creative Commons Attribution (CC BY) license (https://creativecommons.org/licenses/by/4.0/).
Share and Cite
Rozhin, A.; Batasheva, S.; Iskuzhina, L.; Gomzikova, M.; Kryuchkova, M. Antimicrobial and Antifungal Action of Biogenic Silver Nanoparticles in Combination with Antibiotics and Fungicides Against Opportunistic Bacteria and Yeast. Int. J. Mol. Sci. 2024, 25, 12494. https://doi.org/10.3390/ijms252312494
Rozhin A, Batasheva S, Iskuzhina L, Gomzikova M, Kryuchkova M. Antimicrobial and Antifungal Action of Biogenic Silver Nanoparticles in Combination with Antibiotics and Fungicides Against Opportunistic Bacteria and Yeast. International Journal of Molecular Sciences. 2024; 25(23):12494. https://doi.org/10.3390/ijms252312494
Chicago/Turabian StyleRozhin, Artem, Svetlana Batasheva, Liliya Iskuzhina, Marina Gomzikova, and Marina Kryuchkova. 2024. "Antimicrobial and Antifungal Action of Biogenic Silver Nanoparticles in Combination with Antibiotics and Fungicides Against Opportunistic Bacteria and Yeast" International Journal of Molecular Sciences 25, no. 23: 12494. https://doi.org/10.3390/ijms252312494
APA StyleRozhin, A., Batasheva, S., Iskuzhina, L., Gomzikova, M., & Kryuchkova, M. (2024). Antimicrobial and Antifungal Action of Biogenic Silver Nanoparticles in Combination with Antibiotics and Fungicides Against Opportunistic Bacteria and Yeast. International Journal of Molecular Sciences, 25(23), 12494. https://doi.org/10.3390/ijms252312494







